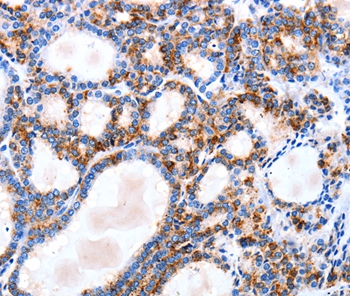

![IGSF6 Mouse Monoclonal Antibody [Clone ID: 104A10.01] IGSF6 Mouse Monoclonal Antibody [Clone ID: 104A10.01]](https://cdn.origene.com/assets/images/antibody/primary-antibody/143/ddx0220p-50-3.png)
IGSF6 Mouse Monoclonal Antibody [Clone ID: 104A10.01]
DDX0220A647-100
ApplicationsFlow Cytometry, Western Blot
Product group Antibodies
TargetIGSF6
Overview
- SupplierOriGene
- Product NameIGSF6 Mouse Monoclonal Antibody [Clone ID: 104A10.01]
- Delivery Days Customer14
- ApplicationsFlow Cytometry, Western Blot
- CertificationResearch Use Only
- ClonalityMonoclonal
- Clone ID104A10.01
- Gene ID10261
- Target nameIGSF6
- Target descriptionimmunoglobulin superfamily member 6
- Target synonymsDORA, immunoglobulin superfamily member 6, down-regulated by activation (immunoglobulin superfamily)
- HostMouse
- IsotypeIgG1
- Protein IDO95976
- Protein NameImmunoglobulin superfamily member 6
- Scientific DescriptionIGSF6 mouse monoclonal antibody, clone 104A10.01
- Storage Instruction-20°C
- UNSPSC12352203